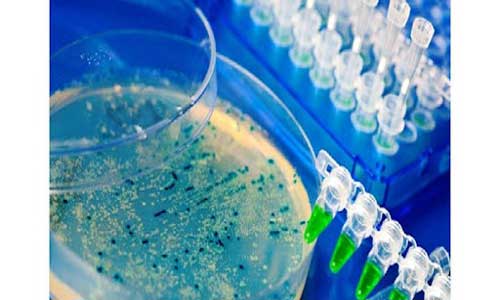

- تعداد بازدید : ۱۴۸ بار
فعالیت موجودات زنده مانند جلبک ها، قارچ ها، باکتری های هوازی و بی هوازی، صدف ها، کپک ها و غیره، شرایط محیطی سیستم ها را نامساعد می سازد. این موجودات قادرند در محدوده وسیع pH و دما و فشار، در محیط های مختلف مانند آب، خاک، نفت و مشتقات نفتی زندگی کنند. روش های گسترده ای برای از بین بردن این مشکلات وجود دارد که از متداول ترین آن ها می توان به استفاده از مواد شیمیایی مانند انواع بایوساید اشاره کرد.
میکرواورگانیسم ها یا مواد شیمیایی که برای نابودی هرگونه میکروب، باکتری، کپک و قارچ مضر به کار برده می شوند، بایوساید، آنتی باکتریال، باکتری کش یا زیست کش نامیده می شود. در واقع بایوساید ها به مواد شیمیایی گفته می شوند که برای نابودی یا کنترل هر گونه میکروارگانیسم مضر از روی سطوح و برخی سیالات به کار برده می شوند. در واقع گاهی بایوسایدها به عنوان عوامل ضد رسوب یا ضد عفونی کننده نیز مورد استفاده قرار می گیرند.
بایوساید چیست
انواع بایوساید ها
بایوسایدها بر اساس صنعت مورد مصرف و پایه شیمیایی به هفت دسته تقسیم بندی می شوند:
ایزوتیازولین
بر پایه پروکسی استیک اسید
بر پایه دی متیل بنزو آلکونیوم کلراید
گلوتار آلدئید
دی برمو نیتریلوپروپین آمید
THPS
آب ژاول
اما اگر بایوسایدها را با توجه به مکانیسم اثر، بررسی کرد می بینیم که به دو دسته زیر تقسیم بندی می شوند:
۱- بایوسایدهای اکسید کننده شامل: ترکیبات کلر، دی اکسید کلر، پراکسید هیدروژن، برم و ازن. این بایوسایدها از طریق فرآیند الکتروشیمیایی اکسیداسیون، باکتری ها را از بین می برد. جایی که زیست کش الکترون را از باکتری به دست می آورد و این از دست دادن الکترون اساساً باکتری ها را از بین می برد.
۲- بایوسایدهای غیراکسید کننده شامل: ترکیبات آمونیوم کوارتز، ایزوتیازولین، برونوپل، THPS ، DBNPA و گلوتارآلدئید. بایوسایدهای غیر اکسید کننده ها معمولاً به صورت تجویزی استفاده می شوند و در صورت وجود چالش های خاص با آب نسبت به رشد بیولوژیکی خاص، کیفیت آب، pH ، محدودیت تخلیه، سمیت، متالورژی و ایمنی شیمیایی وجود دارد.
نکته: به طور کلی می توان از بایوساید های اکسید کننده در غلظت های کمتری نسبت به بایوسایدهای غیر اکسید کننده استفاده می شود و استفاده از آن ها مقرون به صرفه تر است. همچنین استفاده مداوم از یک نوع زیست کش غیر اکسید کننده منجر به رسوب گذاری میکروبی در سیستم آب می شود. برای حل این مشکل باید حداقل از دو نوع بایوساید غیر اکسید کننده در سیستم بسته یا سیستم خنک کننده باز استفاده شود.
مشخصات اطلاعات شرکت فروشنده این محصول
فعالیت موجودات زنده مانند جلبک ها، قارچ ها، باکتری های هوازی و بی هوازی، صدف ها، کپک ها و غیره، شرایط محیطی سیستم ها را نامساعد می سازد. این موجودات قادرند در محدوده وسیع pH و دما و فشار، در محیط های مختلف مانند آب، خاک، نفت و مشتقات نفتی زندگی کنند. روش های گسترده ای برای از بین بردن این مشکلات وجود دارد که از متداول ترین آن ها می توان به استفاده از مواد شیمیایی مانند انواع بایوساید اشاره کرد.
میکرواورگانیسم ها یا مواد شیمیایی که برای نابودی هرگونه میکروب، باکتری، کپک و قارچ مضر به کار برده می شوند، بایوساید، آنتی باکتریال، باکتری کش یا زیست کش نامیده می شود. در واقع بایوساید ها به مواد شیمیایی گفته می شوند که برای نابودی یا کنترل هر گونه میکروارگانیسم مضر از روی سطوح و برخی سیالات به کار برده می شوند. در واقع گاهی بایوسایدها به عنوان عوامل ضد رسوب یا ضد عفونی کننده نیز مورد استفاده قرار می گیرند.
بایوساید چیست
انواع بایوساید ها
بایوسایدها بر اساس صنعت مورد مصرف و پایه شیمیایی به هفت دسته تقسیم بندی می شوند:
ایزوتیازولین
بر پایه پروکسی استیک اسید
بر پایه دی متیل بنزو آلکونیوم کلراید
گلوتار آلدئید
دی برمو نیتریلوپروپین آمید
THPS
آب ژاول
اما اگر بایوسایدها را با توجه به مکانیسم اثر، بررسی کرد می بینیم که به دو دسته زیر تقسیم بندی می شوند:
۱- بایوسایدهای اکسید کننده شامل: ترکیبات کلر، دی اکسید کلر، پراکسید هیدروژن، برم و ازن. این بایوسایدها از طریق فرآیند الکتروشیمیایی اکسیداسیون، باکتری ها را از بین می برد. جایی که زیست کش الکترون را از باکتری به دست می آورد و این از دست دادن الکترون اساساً باکتری ها را از بین می برد.
۲- بایوسایدهای غیراکسید کننده شامل: ترکیبات آمونیوم کوارتز، ایزوتیازولین، برونوپل، THPS ، DBNPA و گلوتارآلدئید. بایوسایدهای غیر اکسید کننده ها معمولاً به صورت تجویزی استفاده می شوند و در صورت وجود چالش های خاص با آب نسبت به رشد بیولوژیکی خاص، کیفیت آب، pH ، محدودیت تخلیه، سمیت، متالورژی و ایمنی شیمیایی وجود دارد.
نکته: به طور کلی می توان از بایوساید های اکسید کننده در غلظت های کمتری نسبت به بایوسایدهای غیر اکسید کننده استفاده می شود و استفاده از آن ها مقرون به صرفه تر است. همچنین استفاده مداوم از یک نوع زیست کش غیر اکسید کننده منجر به رسوب گذاری میکروبی در سیستم آب می شود. برای حل این مشکل باید حداقل از دو نوع بایوساید غیر اکسید کننده در سیستم بسته یا سیستم خنک کننده باز استفاده شود.
مشخصات اطلاعات شرکت فروشنده این محصول














